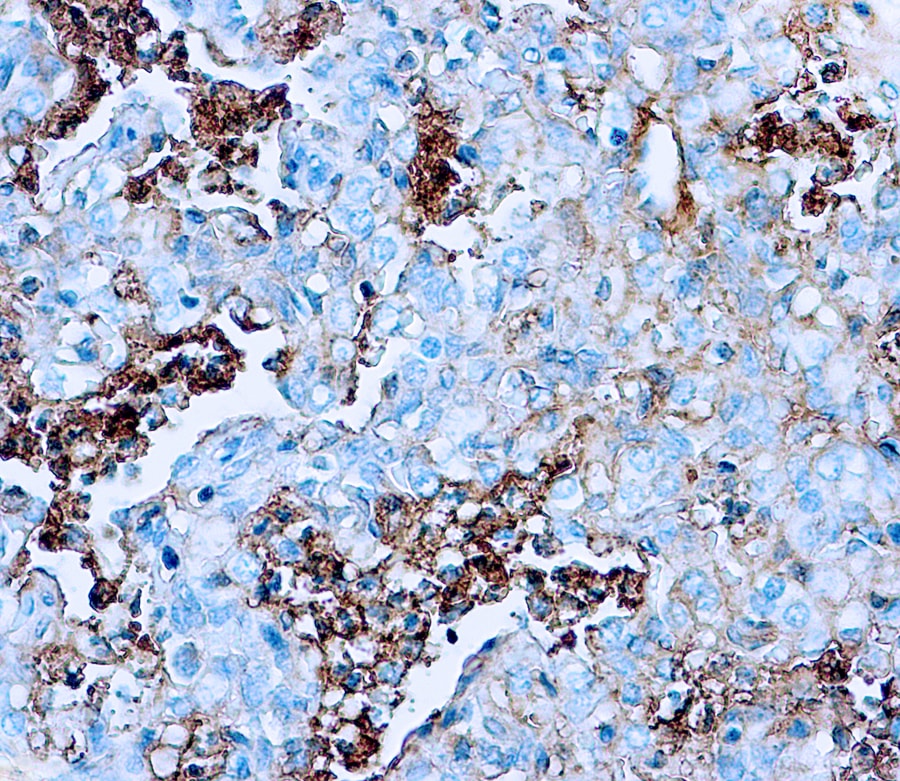

This antibody reacts with human albumin. This antibody is essentially free of other rabbit serum proteins. Specificity is determined by Ouchterlony double diffusion (ODD) and immunoelectrophoresis (IEP) versus human serum and human albumin.
0.5ml
| Clone | Polyclonal Rabbit |
| Isotype | n.a |
| Application | IHC |
La documentation sera disponible sous peu. En attendant, vous pouvez nous contacter par email à l'adresse specialist@histoline.com